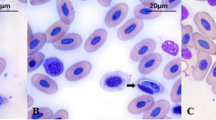

Abstract
The purpose of this study was to perform a phylogenetic analysis of Hepatozoon spp. infecting Philodryas patagoniensis in Uruguay. Twenty-five road-killed specimens of P. patagoniensis from ten departments were obtained. Samples of blood and/or heart tissue were taken. Polymerase chain reaction (PCR) assay was carried out amplifying a specific target region of the 18S rRNA gene of Hepatozoon spp. Eighteen out of twenty-five samples were positive to Hepatozoon spp., which gave an overall prevalence of 72%. Phylogenetic analyses with the obtained sequences were carried out to determine the relationship with closely related species found in the region. The results revealed that samples were split into two clades with a high bootstrap support. Clade I was formed with Hepatozoon spp. sequences obtained in this study from P. patagoniensis, Hepatozoon cuestensis from Crotalus durissus terrificus and Hepatozoon musa from Philodryas nattereri, and Hepatozoon spp. retrieved from Cerdocyon thous, Hemidactylus mabouia, and Phyllopezus pollicaris from Brazil, respectively. Clade II was grouped with Hepatozoon cevapii and Hepatozoon massardii, both species described for C. d. terrificus from Brazil. This is the first report of Hepatozoon spp. in snakes from Uruguay.
Similar content being viewed by others
Avoid common mistakes on your manuscript.
Introduction
The phylum Apicomplexa is a diverse group of obligatory parasites. It is estimated that currently, only 0.1% of the species from this phylum have been described (Morrison 2009). The genus Hepatozoon Miller, 1908 comprises more than 340 species of apicomplexan parasites closely related to piroplasmids and haemosporids, infecting a wide variety of amphibians, reptiles, birds, and mammals (Smith 1996; Baneth et al. 2003). The life cycle of Hepatozoon spp. involves sexual reproduction and sporogony in arthropods that serve both as vectors and as definitive hosts. To date, ticks (Ixodid and Argasid), mites (Acari), mosquitoes (Culicidae), sandflies (Phlebotominae), flies (Diptera), fleas (Siphonaptera), sucking lice (Anoplura), and triatomid bugs (Hemiptera) have been described as the definitive hosts of these parasites. Meanwhile, merogony followed by gametogony occur in vertebrate intermediate hosts. Arthropods acquire the infection by feeding on vertebrate blood cells infected with parasite gametocytes. Interestingly, vertebrates do not become infected through tick or insect bites as other apicomplexan such as Babesiidae family. Instead, the infected arthropods have to be ingested (Smith 1996). Species of Hepatozoon are commonly found parasitizing snakes, with several species described from snake hosts, such as Hepatozoon cuestensis O’Dwyer, Moço, Paduan, Spenassatto, Silva, and Ribolla, 2013, Hepatozoon terzii (Sambon and Seligman, 1907), and Hepatozoon musa Borges-Nojosa, Borges-Leite, Maia, Zanchi-Silva, da Rocha Braga, and Harris 2017 (Smith et al., 1999; Paperna and Lainson 2004; O’Dwyer et al., 2013; Borges-Nojosa et al., 2017).
Philodryas patagoniensis Girard, 1857 (Serpentes: Dipsadidae) is a South American snake with a wide distribution across Argentina, Bolivia, Brazil, and Paraguay. In Uruguay, P. patagoniensis is found throughout the country in a variety of habitats. It is considered a broadly-generalist snake, feeding on arthropods (spiders and ants), fishes, and amphibians, and also on other reptiles (such as saurians, amphisbaenians, ophidians, and even its same species), rodents and birds (Carreira and Maneyro 2013). To date, three species of Hepatozoon have been previously identified in snakes from Philodryas Wagler, 1830 genus. Hepatozoon philodryasi (Carini, 1910) from P. patagoniensis (reported as P. schottii), Hepatozoon butantanensis (Pessoa, 1928) from Philodryas aestiva (Duméril, Bibron and Duméril, 1854), and lastly, H. musa from Philodryas nattereri Steindachner, 1870; all the species were described in Brazil (Carini 1910; Pessoa 1928; Smith 1996; Borges-Nojosa et al., 2017).
The aim of this study was to molecularly characterize and compare the phylogenetic relationships among the Hepatozoon spp. detected in road-killed P. patagoniensis in Uruguay using a fragment of 18S rRNA gene.
Materials and methods
Sample collection
Twenty-five road-killed specimens of P. patagoniensis from ten departments of Uruguay were obtained (Fig. 1). The snakes were placed in individual plastic bags, identified, and kept with cool packs until arrival at the laboratory. Collection data are presented in Table 1. Species identification of collected snakes was done following Carreira and Maneyro (2013).
At the laboratory, blood was obtained directly from the heart, aorta, or vena cava. The samples were collected in 5 ml tubes with ethylenediaminetetraacetic acid (EDTA) and kept frozen at − 20 °C until DNA extraction. When the whole blood could not be extracted, heart tissue was retrieved. Blood smears from a single fresh road-killed specimen (V38) were prepared at the site of collection. Smears were air-dried, fixed with methanol, and stained with 1:9 May-Grünwald-Giemsa diluted in distilled water (Droguería Industrial Uruguaya, Uruguay). Compound microscope (Nikon E-200) was used for examination of slides under × 400 magnification.
DNA isolation, amplification, and sequencing
DNA was extracted from heart tissue and whole blood samples using the commercial kit PureLink™ Genomic DNA Mini Kit (Invitrogen, Germany), following the manufacturer’s instructions. DNA of Hepatozoon sp. was amplified using PCR with the primers HEMO1 (5′-TAT TGG TTT TAA GAA CTA ATT TTA TGA TTG-3′) and HEMO2 (5′-CTT CTC CTT CCT TTA AGT GAT AAG GTT CAC-3′). These primers amplify region of approximately 900 bp of 18S rRNA gene. Primers were designed by Perkins and Keller (2001), and PCR conditions were used following Harris et al. (2011). A second PCR was performed using the primer set HEP1mod (5′-CGC GAA ATT ACC CAA TTC TA - 3′) and HEP4 (5′-TAA GGT GCT GAA GGA GTC GTT TAT-3′) as described by Spolidorio et al. (2009). The second PCR cycle targeted a region of approximately 670 bp of the same gene. These primer pairs were selected because the fragments overlapped thus, a longer sequence (about 1300 bp) could be obtained. A positive (Hepatozoon canis) and negative (DNAse-free water) control were included in each reaction. PCR products were visualized under UV transillumination in a 1.5% agarose gel stained with GoodView™ Nucleic Acid Stain (Beijing SBS Genetech Co., LTd). The positive PCR products were purified using a PureLink™ Quick PCR Purification kit (Invitrogen, Germany) and sent to a commercial sequencing company (Macrogen Inc., Seoul, Korea).
Phylogenetic analysis
All the alignments and phylogenetic analysis were performed using MEGA 7 (Kumar et al. 2016). Each sequence was carefully checked and manual corrections were done when necessary. The two overlapping fragments of each sample were used to assemble a consensus sequence. The sequences obtained in this study were aligned with sequences retrieved from GenBank using MUSCLE algorithm. A phylogeny was constructed using the maximum likelihood (ML) algorithm. Best fitting evolutionary model for 18S rRNA gene was Tamura 3 parameters with gamma distribution. The support of the internal branching of the ML tree was assessed using 1000 bootstrap replicates. Adelina grylli Butaeva 1996 and Adelina dimidiata Schneider 1875 were used as outgroup.
Results
Morphology of the gamonts
The examination of the blood smears obtained from the V38 sample of P. patagoniensis, revealed the presence of Hepatozoon gamonts (Fig. 2). The gamonts showed a stout form, elongated shape with the ends broad and rounded. In some of the erythrocytes, a small elongation was evidenced, and the nucleus was displaced to a centrolateral position when the parasite was present. The mean measurements of the gamonts (n = 6) were the following: length 13.45 μ (11.60–15.00), width 4.83 μ (4.10–6.00), nucleus length 5.30 μ (4.40–6.00), nucleus width 3.53 μ (3.00–4.00). The measurements of the parasitized erythrocyte were the following: length 18.33 μ (17.50–20.00) and width 11.98 μ (9.60–14.00).
PCR and sequencing
A total of 18 out of 25 (72%) samples were positive for Hepatozoon spp. Fifteen samples were successfully amplified using both primer sets. The remaining three samples could only be amplified using a single primer set (Table 2). After assembling the overlapping fragments of each sample, the sequence lengths varied from 1199 to 1326 bp. Sequences obtained from the samples, V01, V02, V06, V10, V11, V14, V17, V19, V20, V21, V22, V35, V36, V37, and V38 have been submitted to GenBank (accession numbers MN003356 to MN003370, respectively).
Phylogenetic analysis
All the sequences obtained in this study were aligned with sequences retrieved from GenBank from various host species, and the final datasets contained a total of 45 sequences. Due to the difference in length of the available registered haemogregarines sequences, the tree was constructed using a fragment of 1250 bp. Therefore, three positive samples (V09, V15, and V18) could not be included in the tree due to the short length. These three sequences showed an identity of 99% with H. musa from P. nattereri and two species of Hepatozoon sp. from Hemidactylus mabouia Moreau De Jonnès, 1818 and Rhinella schneideri Werner, 1894, respectively (GenBank accession numbers, KX880079, KM234615, and MK508987). The phylogenetic analysis showed that the Hepatozoon spp. sequences obtained from P. patagoniensis of Uruguay are grouped in two monophyletic clades with a high bootstrap support (Fig. 3). Clade I was compound by 14 sequences obtained from P. patagoniensis (V01, V02, V10, V11, V14, V17, V19, V20, V21, V22, V35, V36, V37, and V38) and H. musa from P. nattereri, H. cuestensis from Crotalus durissus terrificus (Laurenti, 1768) and Hepatozoon spp. from the hosts Cerdocyon thous (Linnaeus, 1766), Hem. mabouia, and Phyllopezus pollicaris Spix, 1825. Clade II was constituted by V06 obtained from P. patagoniensis and sequences of Hepatozoon massardii O’Dwyer, Moço, Paduan, Spenassatto, Silva, and Ribolla, 2013, and Hepatozoon cevapii O’Dwyer, Moço, Paduan, Spenassatto, Silva, and Ribolla, 2013. Both species were described in C. d. terrificus from Brazil (Fig. 3).
Maximum likelihood tree constructed of Hepatozoon spp. partial 18S rRNA gene sequences. Numbers represent bootstrap support generated from 1000 replicates. The sequences obtained in this study were highlighted in bold. GenBank accession numbers are in brackets. Adelina spp. were included as outgroup. Brunch supporting value > 60 are shown
Discussion
To date, there are only few published studies on Hepatozoon spp. from naturally infected Philodryas snakes (Carini 1910; O’Dwyer et al., 2003; Moço 2008; Borges-Nojosa et al., 2017). In this study, the observed prevalence of Hepatozoon spp. in P. patagoniensis, collected as roadkills, was 72%. The prevalence of Hepatozoon spp. reported in the current study was higher as compared with O’Dwyer et al. (2003) that reported a prevalence of 16% of Hepatozoon spp. in other members of the genus Philodryas. Furthermore, Moço (2008) screened nine P. patagoniensis without detecting the presence of Hepatozoon spp. These studies used only microscopy screening to determine prevalence of Hepatozoon spp. Borges-Nojosa et al. (2017) reported a low prevalence (14.3%) of species of Hepatozoon from seven P. nattereri in Northeastern Brazil.
One of the main drawbacks describing new species is the limited available information. For instance, in the past, most of the studies were based on morphological descriptions (Carini 1910, Pessoa, 1928). The risk of defining species based only on a single method (i.e., morphology of blood forms) was already recognized several decades ago (Ball 1958; Ball et al. 1967). However, as in O’Dwyer et al. (2013) and Borges-Nojosa et al. (2017), the present study combines morphological and molecular techniques for the characterization of Hepatozoon spp. from P. patagoniensis. Furthermore, in the present study, molecular techniques were shown to be a useful tool for characterization of Hepatozoon spp. from snake roadkills.
The morphometry of gamonts found on sample V38 were compatible with those found for H. philodryasi, the only species of Hepatozoon described from P. patagoniensis (Carini 1910; Moço et al. 2002). Furthermore, some of the analyzed gamonts showed an ovoid form, similar to H. butantanensis reported from P. aestiva (Pessoa, 1928). Although, the vermicular forms of H. butantanensis were larger as compared with the gamont forms reported in our study (up to 23 μ in length). On the other hand, the gamonts described as H. musa, found in P. nattereri were elongated (Borges-Nojosa et al. 2017), with a significant curvature at both ends and longer than those from our findings but similar to those described as the vermicular forms of H. butantanensis.
A problem in morphological-based studies is the polymorphism presented by the gamonts of certain species. For example, Smith (1996) mentioned three different forms of Hepatozoon gamonts in the blacktail rattlesnake Crotalus molossus molossus Baird and Girard, 1853. The same author reported the existence of immature and mature gamonts, and these developmental stages could be misdiagnosed as different species (Smith 1996). Much of this variability in the gamont structure could be attributed to the coexistence of different developmental stages in a single blood smear (O’Dwyer et al. 2013). According to Smith et al. (1994), snakes undergoing merogony may contain gamonts of different sizes and shapes representing immature or mature forms. As for snakes screened in South America, Moço et al. (2002) studied the morphology and morphometrics of gamonts such as length and surface as well as displacement of nucleus of parasitized erythrocytes of several species of Hepatozoon. The authors mentioned that H. terzii, H. philodryasi and a Hepatozoon sp. from C. d. terrificus could not be distinguished between. Some reports have demonstrated that the same Hepatozoon species could infect different hosts (Hull and Camin 1960; Pessoa et al. 1971). Besides, the gamonts of a same species of Hepatozoon could present slight morphologic changes and different cytopathological effects on the infected blood cells depending on the host (Ball et al. 1967; Pessoa et al. 1974). Some researchers (Pessoa et al. 1971, Smith 1996) argue that there is a possibility that some of the species of Hepatozoon described for terrestrial snakes are, in fact, the same species presenting pleomorphic blood forms that could vary depending on the vertebrate host.
The phylogenetic analysis performed using 18S rDNA sequences of Hepatozoon spp. from P. patagoniensis collected in Uruguay demonstrated that our samples are divided in two clades, with high bootstrap support (Fig. 3). All the obtained sequences from the present study (clade I), with the exception of one sample (V06), grouped with H. cuestensis, H. musa and Hepatozoon spp. found parasitising P. pollicaris, Hem. mabouia, and C. thous, respectively. According to our phylogenetic analysis, H. musa was shown to be closely related to H. cuestensis, and the other Hepatozoon sp. obtained in this study (Fig. 3). In contrast, sample V06 formed a separate clade (II) along with sequences of H. cevapii and H. massardii described from C. d. terrificus (O’Dwyer et al. 2013). For a proper species discrimination, further studies must be carried out with a larger number of samples from each Hepatozoon species. In our study, we showed the presence of two clades of Hepatozoon parasitizing P. patagoniensis from a restricted area of Uruguay. It is possible that some of the recently described species correspond to H. philodryasi or H. butantanensis, previously described from snakes of the genus Philodryas. Unfortunately, there are no molecular data available for H. philodryasi or H. butantanensis that could either confirm or deny this hypothesis. In agreement with Moço et al. (2002) and Maia et al., (2012), description of new Hepatozoon species must be carried out combining exhaustive morphological and molecular studies with longer fragments or full length of the 18S rRNA gene. This study showed that it is possible that some of the species described only using morphological features or short fragments of 18S rRNA gene could be the same species. Therefore, further studies on haemogregarines should include detailed morphological and extensive molecular data.
References
Ball GH (1958) A haemogregarine from a water snake, Natrix piscator taken in the vicinity of Bombay, India. J Protozool 5:274–281. https://doi.org/10.1111/j.1550-7408.1958.tb02566.x
Ball GH, Chao J, Telford SR (1967) The life history of Hepatozoon rarefaciens (Sambon and Seligmann 1907) from Drymarchon corais (Colubridae), and its experimental transfer to Constrictor constrictor (Boidae). J Parasitol 53:897–909. https://doi.org/10.2307/3276805
Baneth G, Mathew JS, Shkap V, Macintire DK, Barta JR, Ewing SA (2003) Canine hepatozoonosis: two disease syndromes caused by separate Hepatozoon spp. Trends Parasitol 19:27–31. https://doi.org/10.1016/S1471-4922(02)00016-8
Borges-Nojosa DM, Borges-Leite MJ, Maia JP, Zanchi-Silva D, da Rocha BR, Harris DJ (2017) A new species of Hepatozoon Miller, 1908 (Apicomplexa: Adelerina) from the snake Philodryas nattereri Steindachner (Squamata: Dipsadidae) in Northeastern Brazil. Syst Parasitol 94(1):65–72 https://doi.org/10.1007/s11230-016-9676-2
Carini A (1910) Sobre uma hemogregarina de Philodryas schottii. Rev Med S Paulo 23:339–340
Carreira S, Maneyro R (2013) Guía de Reptiles del Uruguay. Ediciones de la Fuga, Montevideo
Harris DJ, Maia JP, Perera A (2011) Molecular characterization of Hepatozoon species in reptiles from the Seychelles. J Parasitol 97(1):106–110. https://doi.org/10.1645/GE-2470.1
Hull RW, Camin JH (1960) Haemogregarine in snakes: the incidence and identity of the erythrocytic stages. J Parasitol 46:515–523 https://doi.org/10.2307/3275151
Kumar S, Stecher G, Tamura K (2016) MEGA7: molecular evolutionary genetics analysis version 7.0 for bigger datasets. Mol Biol Evol 33(7):1870–1874. https://doi.org/10.1093/molbev/msw054
Maia JP, Perera A, Harris DJ (2012) Molecular survey and microscopic examination of Hepatozoon Miller, 1908 (Apicomplexa: Adeleorina) in lacertid lizards from the western Mediterranean. Folia Parasit 59(4):241–248
Moço TC (2008) Prevalência de Hepatozoon spp. em serpentes e caracterização morfológica, morfométrica e molecular de Hepatozoon spp.(Apicomplexa, Hepatozoidae) de Crotalus durissus terrificus (Serpentes, Viperidae) naturalmente infectadas. Tesis de Maestría, Programa de PósGraduação em Biologia Geral e Aplicada, Área de concentração Biologia de Parasitas Instituto de Biociências, Câmpus de Botucatu, Universidade Estadual Paulista (UNESP)
Moço TC, O’Dwyer LH, Vilela FC, Barrella TH, Silva RJ (2002) Morphologic and morphometric analysis of Hepatozoon spp. (Apicomplexa, Hepatozoidae) of snakes. Mem Inst Oswaldo Cruz 97:1169–1176 https://doi.org/10.1590/S0074-02762002000800019
Morrison DA (2009) Evolution of the Apicomplexa: where are we now? Trends Parasitol 25(8):375–382. https://doi.org/10.1016/j.pt.2009.05.010
O’Dwyer LH, Moço TC, dos Santos PK, Spenassatto C, da Silva RJ, Ribolla PEM (2013) Description of three new species of Hepatozoon (Apicomplexa, Hepatozoidae) from rattlesnakes (Crotalus durissus terrificus) based on molecular, morphometric and morphologic characters. Exp Parasitol 135(2):200–207. https://doi.org/10.1016/j.exppara.2013.06.019
O’Dwyer LH, Moço TC, Barrella TH, Vilela FC, Silva RJ (2003) Prevalence of Hepatozoon spp. (Apicomplexa, Hepatozoidae) among recently captured Brazilian snakes. Arq Bras Med Vet Zootec 55(3):309–314 https://doi.org/10.1590/S0102-09352003000300010
Paperna I, Lainson R (2004) Hepatozoon cf. terzii (Sambon & Seligman, 1907) infection in the snake Boa constrictor constrictor from North Brazil: transmission to the mosquito Culex quinquefasciatus and the lizard Tropidurus torquatus. Parasite 11:175–181. https://doi.org/10.1051/parasite/2004112175
Perkins SL, Keller AK (2001) Phylogeny of nuclear small subunit rRNA genes of hemogregarines amplified with specific primers. J Parasitol 87:870–876. https://doi.org/10.1645/0022-3395(2001)087[0870:PONSSR]2.0.CO;2
Pessoa SB (1928) Contribuição ao estudo dos hemoparasitas dos ofídios. III. Haemogregarina butantanensis n. sp. Parasita do Philodryas aestivus. Bol Ins Hyg 35:56–61
Pessoa SB, Belluomini HE, De Biasi P, De Souza DM (1971) Notas sobre hemogregarinas de serpentes brasileiras. XIV - Esporogonia da hemogregarina da Bothrops moojeni Hoge, 1965 no Culex (Culex) dolosus, (L. Arribálzaga, 1891). Arq Inst Biol São Paulo 38:253–258
Pessoa SB, De Biasi P, Puorto G (1974) Transferência do Hepatozoon tupinambis, parasita do lagarto Tupinambis teguixin, para a serpente cascavel (Crotalus durissus terrificus) por intermédio de mosquito Culex fatigans. Mem Inst Oswaldo Cruz 72:295–299 https://doi.org/10.1590/S0074-02761974000200013
Smith TG (1996) The genus Hepatozoon (Apicomplexa: Adeleina). J Parasitol 82:565–585. https://doi.org/10.2307/3283781
Smith TG, Desser SS, Martin DS (1994) The development of Hepatozoon sipedon (Apicomplexa: Adeleina: Hepatozoidae) in its natural host, the northern water snake (Nerodia sipedon sipedon), the culicine vectors, Culex pipiens and Culex territans, and in an intermediate host, the northern leopard frog (Rana pipiens). Parasitol Res 80:559–568. https://doi.org/10.1007/BF00933003
Smith TG, Kim B, Desser SS (1999) Phylogenetic relationships among Hepatozoon species from snakes, frogs, and mosquitoes of Ontario, Canada, determined by ITS-1 nucleotide sequences and life-cycle, morphological and developmental characteristics. Int J Parasitol 29:293–304 https://doi.org/10.1016/S0020-7519(98)00198-2
Spolidorio MG, Labruna MB, Zago AM, Donatele DM, Caliari KM, Yoshinari NH (2009) Hepatozoon canis infecting dogs in the State of Espírito Santo, Southeastern Brazil. Vet Parasitol 163:357–361. https://doi.org/10.1016/j.vetpar.2009.05.002
Acknowledgments
We are grateful to Martín Martinicorena and Mauricio Burutarán for providing some of the samples. Thanks to the two anonymous reviewers for their comments and suggestions that greatly improve the quality of our manuscript.
Author information
Authors and Affiliations
Corresponding author
Ethics declarations
Conflict of interest
The authors declare that they have no conflict of interest.
Additional information
Section Editor: Leonhard Schnittger
Publisher’s note
Springer Nature remains neutral with regard to jurisdictional claims in published maps and institutional affiliations.
Rights and permissions
About this article
Cite this article
Bazzano, V., Félix, M.L., Parodi, P. et al. Phylogenetic analysis of Hepatozoon spp. (Apicomplexa: Hepatozoidae) infecting Philodryas patagoniensis (Serpentes: Dipsadidae) in Uruguay. Parasitol Res 119, 1093–1100 (2020). https://doi.org/10.1007/s00436-020-06605-7
Received:
Accepted:
Published:
Issue Date:
DOI: https://doi.org/10.1007/s00436-020-06605-7